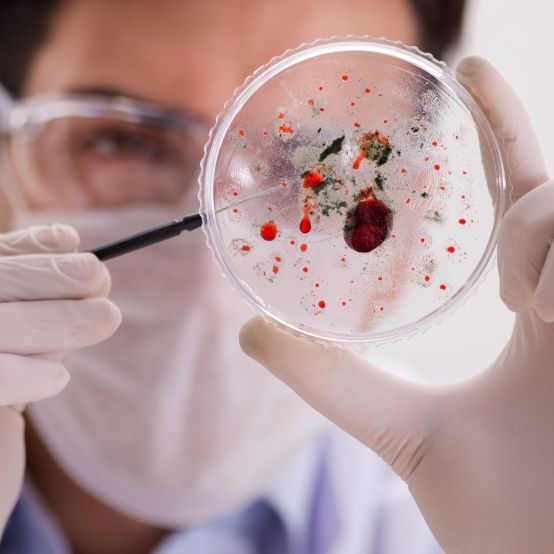
Experten sind besorgt - diese Viren könnten die nächste Pandemie auslösen

Antikörper mit breitem Schutz, neue Ansätze gegen Long Covid und soziale Vertrauensverluste: Niedersachsens Corona-Forschungsnetzwerk zieht nach fünf Jahren Bilanz.

Antikörper mit breitem Schutz, neue Ansätze gegen Long Covid und soziale Vertrauensverluste: Niedersachsens Corona-Forschungsnetzwerk zieht nach fünf Jahren Bilanz.

Drei Tote, sechs Infizierte und über 140 Menschen in der Virus-Falle: Das Kreuzfahrtschiff "MV Hondius" ist in Teneriffa angekommen, wo nun eine der aufwendigsten Evakuierungsaktionen seit der Corona-Pandemie läuft – unter den Augen des WHO-Chefs persönlich.

Das Corona-Virus hat sich rasend schnell verbreitet und eine globale Pandemie ausgelöst. Welche furchterregenden Todes-Seuchen in früheren Zeiten die Menschheit auszulöschen drohten, erfahren Sie hier.

Nach dem Meningitis-Ausbruch in Südengland breitet sich die tödliche Krankheit weiter aus. Zwei junge Menschen sind bereits gestorben, Tausende wurden bereits vorsorglich behandelt. Ist Meningitis das neue Covid?

Ein mutiertes, bei Nutztieren verbreitetes Influenza-Virus könnte Experten zufolge die nächste Pandemie in Gang setzen. Forscher warnen bereits: Nur minimale Mutationen könnten ausreichen, damit sich der Erreger von Mensch zu Mensch verbreitet.

Nachdem das Oropouche-Fieber vergangenes Jahr auch in Deutschland angekommen ist, steigt die Angst vor einer erneuten Seuchengefahr. Und auch das Nipah-Virus in Indien grassiert derzeit. Wie hoch ist das aktuelle Seuchenpotential und droht gar eine neue Pandemie?
Während die Welt noch mit den Nachwirkungen von Covid-19 kämpft, haben Wissenschaftler bereits vier Erreger im Visier, die 2026 zur nächsten Pandemie führen könnten. In einigen Ländern kam es bereits zu Virusausbrüchen.

Der Beginn eines neuen Jahres ist seit jeher die Zeit, in der sich selbsternannte Hellseher auf Zukunftsprognosen verlegen. Die nun für 2026 veröffentlichten Prophezeiungen für 2026 dürften weder Donald Trump noch König Charles III. gefallen.

Vor fast sechs Jahren rollte die Corona-Welle nach Deutschland. Ging alles mit rechten Dingen zu, als der Bund versuchte, das Gesundheitswesen vor einem Kollaps zu schützen?

Die Entwicklung des Vogelgrippe-Erregers H5N1 bereitet Experten Kopfzerbrechen: Analysen der Weltgesundheitsorganisation zufolge entwickelt sich das Virus schneller als je zuvor und stellt die Impfstoff-Entwicklung vor ein Dilemma.

Virus-Alarm aus den USA: Erstmals ist bei einem Menschen eine Infektion mit dem Vogelgrippe-Subtyp H5N5 nachgewiesen worden. Wie es dem Betroffenen aktuell geht und wie sich die Infektion auf die Pandemie-Gefahr auswirkt, erfahren Sie hier.

Der Ukraine-Krieg könnte einem Mediziner zufolge noch bislang ungeahnte Konsequenzen für die gesamte Welt haben. Der Ausbruch einer neuen Pandemie sei möglich. So begründet Dr. Amesh Adalja seine Warnung in einem Podcast.

In Zentralafrika hat ein erneuter Ausbruch des gefährlichen Ebola-Fiebers bereits 15 Menschenleben gefordert - die Weltgesundheitsorganisation WHO rechnet mit weiteren Infektionen und Todesfällen. Bahnt sich eine neue Pandemie an?

In Deutschland gilt die Pest als ausgerottet, doch in den USA grassiert der Prest-Erreger Yersinia pestis weiter. Nun hat sich eine Person in Kalifornien beim Camping mit der Mittelalterseuche angesteckt - das ist zu dem Fall bekannt.

Seit der Covid-Pandemie ist die Besorgnis über psychische Krankheiten drastisch gestiegen. Nicht nur hat sich die Zahl der Kinder in Therapie verdoppelt, auch Essstörungen bei jungen Mädchen treten inzwischen doppelt so häufig auf.

Astronauten könnten vor laufenden Kameras an außerirdischen Krankheitserregern sterben, warnt der Astrobiologe Barry DiGregorio. Der Forscher befürchtet, dass Mars-Missionen mehr als nur Gesteinsproben zurückbringen könnten.

Die EU hat einen neuen Plan vorgelegt, um im Falle eines möglichen 3. Weltkriegs und etwaigen Pandemien entsprechend gerüstet zu sein. "Je besser wir uns vorbereiten, desto weniger geraten wir in Panik", erklärte EU-Kommissarin Hadja Lahbib.

Die Pandemie ist vorbei, doch sie hat Spuren hinterlassen. Nach langem Streit kommt jetzt eine große Auswertung des Krisenmanagements und der Folgen - um Lehren daraus zu ziehen.

Die Corona-Pandemie sorgte für erschütternde Zustände weltweit. Ein neuer Bericht deckt nun fünf Jahre später die irre Corona-Lüge von Nordkorea-Diktator Kim Jong-un auf. Die Details sind erschreckend.

Die heiße Phase der Coronavirus-Pandemie mag die Menschheit überstanden haben, doch schenkt man der Prophezeiung einer gewissen Ryo Tatsuki Glauben, steht die nächste Pandemie mit einem "mysteriösen Virus" bereits unmittelbar bevor.

Diese Meldung dürfte für Beunruhigung sorgen: Chinesische Forschende haben neue Eigenschaften eines Coronavirus in Fledermäusen entdeckt. Das Virus, das auf den Namen HKU5-CoV-2 hört, könnte Menschen infizieren. Wie Experten nun das Gefahrenpotenzial einschätzen.

Chaotische Zustände wie in der Corona-Pandemie sollen sich nicht wiederholen. Deshalb gibt es jetzt einen Pandemievertrag - in dem aber wichtige Details fehlen.

Chaotische Zustände wie bei der Corona-Pandemie sollen sich nicht wiederholen. Die WHO-Mitgliedsländer haben sich jetzt auf einen Pandemievertrag geeinigt.

Diese Worte aus China überraschen: Einem aktuellen Schreiben zufolge sollen die USA Schuld an der verheerenden Coronavirus-Pandemie haben. Was haben die Anschuldigungen mit Donald Trumps Zoll-Krieg gegen China zu tun?

Ein neuartiges Coronavirus in Fledermäusen entdeckt - ausgerechnet aus China! Was sich für viele wie eine echte Horror-Meldung anhört, ist das Ergebnis einer wissenschaftlichen Studie, die nun veröffentlicht wurde. Was man bisher weiß.

Kommt die nächste globale Pandemie aus einem russischen Labor? Angebliche Kreml-Insider enthüllen Unfassbares: Demnach sei in Russland ein Pandemie-Virus erzeugt worden, das Wladimir Putins Machtposition zementieren soll.

Wenn ein tödliches Virus mit Pandemie-Potenzial irgendwo auf der Welt um sich greift, können schon die ersten Schritte entscheidend sein. Ein neuer Vertrag soll eine weltweite Ausbreitung verhindern.

Die weltweite Corona-Pandemie dürfte Experteneinschätzungen zufolge erst der Anfang gewesen sein: Etliche Erreger sind imstande, der Menschheit eine neue tödliche Krankheitswelle zu bescheren. Nun liegt eine Liste mit den gefährlichsten Pandemie-Kandidaten vor.

Urlauber sollten bei der Wahl ihres Reiseziels aktuell besonders vorsichtig sein: In beliebten Destinationen ist ein nicht behandelbares Virus auf dem Vormarsch. Für bestimmte Personengruppen ist das Oropouche-Virus besonders gefährlich.

Die Corona-Pandemie, die vor fünf Jahren ihren Siegeszug antrat, dürfte nicht die letzte globale Seuche gewesen sein: Im Tierreich schlummern unzählige Erreger, die der Menschheit gefährlich werden können, wie die neue ARD-Doku "Spillover - Planet der Viren" beleuchtet.

Hunderte Experten glauben, dass die Welt in zehn Jahren deutlich schlechter sein könnte. Eine Befragung des Atlantic Council offenbart, mit welchen Bedrohungen die Menschheit rechnen muss.

Nach der Corona-Pandemie könnten weitere verheerende Seuchen auf die Menschheit zukommen. Top-Virologe Florian Krammer aus Österreich blickt derzeit mit besonderer Sorge nach Südostasien. Dort grassiert bereits das tödliche Nipah-Virus, welches in Zukunft gefährlich mutieren könnte.

In Afrika haben Wissenschaftler einen neuen Mpox-Stamm entdeckt, der eine erschreckend hohe Sterblichkeitsrate hat. Die Forscher fordern internationale Maßnahmen, um eine mögliche Pandemie zu verhindern.

In den USA breitet sich das Vogelgrippevirus derzeit in Milchbetrieben aus. Bislang besteht zwar keine Gefahr für den Menschen, doch eine künftige Mutation könnte die Gefahr einer neuen Pandemie enorm steigern.

Die Weltgesundheitsorganisation (WHO) rief aufgrund der Ausbreitung des Mpox-Virus, ehemals Affenpocken, unlängst die Notlage aus. Nun gab es auch einen ersten Fall in Deutschland. Experten warnen - was genau bedeutet das?

Immer wieder sorgen Ausbrüche der Vogelgrippe für Schlagzeilen - auch bei Säugetieren wird das H5N1-Virus immer häufiger nachgewiesen. Für Virologen eine alarmierende Entwicklung, die den Ausbruch der nächsten Pandemie näher rücken lässt.

Der Beginn der Corona-Pandemie liegt fünf Jahre zurück, nun ächzt China erneut unter einer mysteriösen Viruswelle. Der noch nicht identifizierte Erreger ist ersten Erkenntnissen zufolge tödlicher als Sars-CoV-2.

Experten sind sich sicher, dass uns früher oder später die nächste Pandemie droht. Ein Top-Virologe erklärt aktuell im Interview, welche Viren diese auslösen könnten. Er warnt nicht nur vor der Vogelgrippe, sondern auch vor dem sogenannten "Erreger X".

China sieht sich aktuell erneut mit einem mysteriösen Virus-Ausbruch konfrontiert. Ersten Vermutungen zufolge soll das humane Metapneumovirus (HMPV) für die gehäuft auftretenden Infektionen verantwortlich sein. Das sollten Sie über das Virus wissen.

Die sogenannte "Krankheit X" breitet sich weiter aus und sorgt bei Forschenden für starke Beunruhigung. Nach wochenlangen Untersuchungen konnte nun der tödliche Erreger der bisher unbekannten Krankheit ermittelt werden.

Nach der Veröffentlichung ungeschwärzter Corona-Protokolle steht der Bundesgesundheitsminister in der Schusslinie: Hat Karl Lauterbach die RKI-Experten politisch beeinflusst und die Entwarnung verzögert?

Im Mittelalter raffte die als "schwarzer Tod" bekannte Beulenpest Millionen Menschen dahin, doch ausgerottet wurde die Krankheit nie gänzlich. In den USA wurde nun ein weiterer Pest-Fall gemeldet - droht eine neue Pandemie?

Es ist eine gruselige Vorstellung. Zwei Jäger sterben nach dem Konsum von Hirschfleisch. US-Forscher warnen, die Männer könnten der "Zombie-Hirsch-Krankheit" zum Opfer gefallen sein. Es ist von "verstörenden Symptomen" die Rede.

Forscher haben in einer neuen Studie das Pandemiepotenzial für verschiedene Erreger benannt. Demnach könnte die Influenza die nächste tödliche Infektionskrankheit auf der ganzen Welt auslösen.

Die staatlichen Maßnahmen zur Eindämmung der Corona-Pandemie waren teils heftig umstritten. Nun sind Protokolle zu Beratungen des RKI-Krisenstabs publik gemacht worden, die erneut heftige Debatten entfachen.

Droht der Menschheit die nächste globale Pandemie? Aktuell breitet sich ein neues unidentifiziertes Virus aus. Während Patienten von Corona-ähnlichen Symptomen berichten, zeigen sich Ärzte ratlos. "Wir wissen nicht, was das ist."

Die Corona-Pandemie forderte nicht nur sieben Millionen Menschenleben, sondern legte auch schonungslos Schwachstellen im Gesundheitswesen offen. Experten fürchten nun, dass eine neue Krankheit-X-Pandemie deutlich heftigere Ausmaße annehmen könnte.

Das Coronavirus kostete weltweit sieben Millionen Menschen das Leben - die nächste Pandemie, die Experten zufolge bereits in den Startlöchern steht, könnte das locker überbieten. Die Vorbereitungen in Expertenkreisen laufen bereits.

An allen Ecken der Erde schlummern gleich mehrere Krankheiten, die Experten Anlass zur Sorge geben: Die aus dem Tierreich stammenden Erreger sind in der Lage, weltweite Pandemien mit verheerenden Folgen auszulösen.

Die Corona-Pandemie wird nicht die letzte tödliche Pandemie gewesen sein, mit der sich die Menschheit auseinander setzen muss. Experten warnen schon jetzt vor "Krankheit X", einem Virus, das tödlicher ist, als Covid-19. Forscher sind in Alarmbereitschaft.
© 2026 MM New Media GmbH